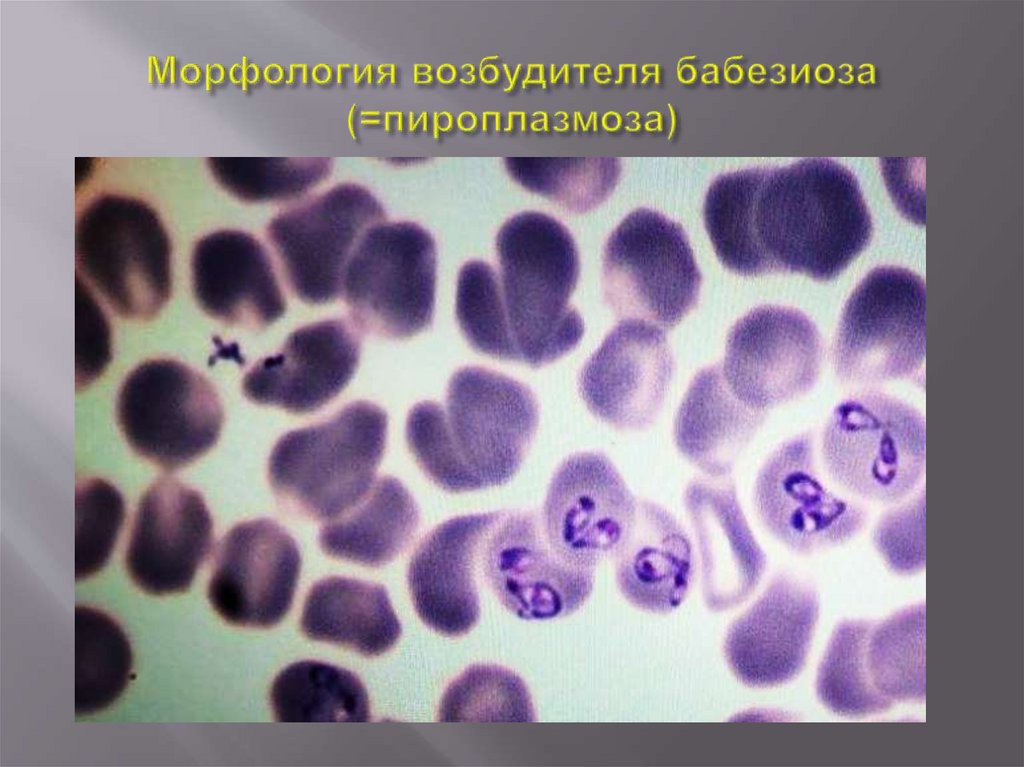

Похожие презентации:
практическое занятие 2
1.
2.
Пироплазмиды – простейшие с гетероксенным жизненным циклом,паразитирующие у позвоночных животных и в клещах надсемейства
Ixodoidea. В организме позвоночных хозяев они развиваются в
эритроцитах и клетках лимфатической системы, в организме
беспозвоночных хозяев – в гемолимфе, клетках стенки кишечника,
яйцевых и других клетках. У клещей-переносчиков пироплазмиды
могут передаваться от одной фазы их развития к другой и
циркулировать трансовариально, от генерации к генерации, и
трансфазно, от одной стадии метаморфоза к другой. Стадии
пироплазмид, инвазирующие позвоночных хозяев, созревают в
слюнных железах клещей. Передача паразитов позвоночным хозяевам
осуществляется клещами при питании кровью.
Простейшие относятся к отряду Piroplasmida, в состав которого входят
два семейства: Babesiidae и Theileriidae.
3.
Систематическое положениеЦарство Protozoa (=Protista)
Тип Apicomplexa
Класс Sporozoa
Отряд Piroplasmida
Семейство Babesiidae
Род Babesia spp.
4.
БАБЕЗИОЗ (=пироплазмоз, франсаиеллез) – остро,подостро и хронически протекающая протозойная,
трансмиссивная, сезонная, природно-очаговая
болезнь
животных,
вызываемая
эндоглобулярными, беспигментными паразитами
рода Babesia и характеризующаяся высокой
температурой, лихорадкой постоянного типа,
анемией и желтушностью слизистых оболочек,
гемоглобинурией,
функциональными
нарушениями всех систем организма, а также
значительным снижением продуктивности и
высокой смертностью заболевших животных.
5.
Babesia круглой, кольцевидной формы, размер паразитаменьше радиуса эритроцита, располагается на периферии,
образует грушевидные пары, угол соединения – тупой, 1
хроматиновая масса в одном паразите, 40 – 60 % гибели
эритроцитов.
Babasia(=Piroplasma) грушевидной формы, размер паразита
больше радиуса эритроцита, центральное расположение в
эритроците, образует грушевидные пары, угол соединения –
острый, 1-4 хроматиновых масс в одном паразите, 10 – 15 %
гибели эритроцитов.
Babesia(=Francaiella) круглой, овальной формы, размер
паразита приравнивается радиусу эритроцита, центральное
расположение в эритроците, образует грушевидные пары,
угол соединения – тупой, 1 хроматиновая масса в одном
паразите, 3 – 15 % гибели эритроцитов.
6.
МОРФОЛОГИЯХарактерные признаки:
Форма
Размер
Расположение в
эритроците
Угол соединения парных форм
7.
8.
Вид животногоВозбудитель
Клещ-переносчик
крупный рогатый скот
Babesia bovis
Ixodes ricinus
I. persulcatus
I. hexagonus
мелкий рогатый скот
B. ovis
Rhipicephalus bursa
9.
Вид животногоВозбудитель
Клещ-переносчик
Крупный рогатый скот
B. (=Piroplasma)
bigemina
Haemaphysalis punctata
Boophilus calcaratus
Rhipicephalus bursа
Мелкий рогатый скот
B. (=Piroplasma) ovis Rh. bursa
Однокопытные
B. (=Piroplasma)
caballi
Собака
B. (=Piroplasma)
canis
свинья
B. (=Piroplama)
trautmanni
Dermacentor pictus
D. marginatus
D. silvarum
Rh. turanicus
Hyalomma plumbeum
Dermacentor pictus
Rh. sanquineus
Ixodes ricinus
Rh. turanicus
Rh. sanquineus
10.
11.
Вид животногоВозбудитель
крупный рогатый скот
Fr. сolchica
Fr. caucasica
мелкий рогатый скот
F. ovis
Клещ-переносчик
Boophilus calcaratus
Rhipicephalus bursa
12.
13.
14.
Мерогония–
это
процесс
бесполого
размножения, в результате которого образуется
многоядерная клетка, заполненная мерозоитами.
Гаметогония – это процесс полового
размножения, в результате которого образуются
половые клетки (гаметы).
Спорогония
- это процесс бесполого
размножения,
в
результате
которого
оплодотворенная клетка многократно делится и
образует спорозоиты.
15.
Диагноз устанавливают с учетом эпизоотологическихданных (наличие определенного клеща на теле животного,
очаг, сезон), клинических признаков (тип лихорадки,
анемичность и желтушность слизистых оболочек,
гемоглобинурия и время ее появления),
патологоанатомических изменений (желтушность тканей,
увеличение селезенки, печени и лимфатических узлов,
кровоизлияния на слизистых и паренхиматозных органах,
завал книжки у жвачных, водянистая кровь и наличие в
мочевой пузыре мочи красного цвета) и подтверждают
лабораторными исследованиями (микроскопия мазков
крови, серологические реакции РСК, РДСК, РИФ, РА)
16.
17.
Инкубационный период -10-14 сутПовышение температуры до 40-420С
Лихорадка постоянного типа
Гемоглобинурия
Дыхание учащается до 70-80 движений в мин,
частота пульса достигает до 90-120 ударов в
мин
Атония преджелудков
18.
Подкожная клетчатка и сухожилия желтушные, слизистыеи серозные оболочки бледные, с желтушным оттенком и
мелкими точечными кровоизлияниями. Лимфатические узлы
увеличены,
сочные
на
разрезе
с
точечными
кровоизлияниями. Мышцы бледные, кровь водянистая,
плохо свертывается. Селезенка увеличена в 2-3 раза, с
закругленными краями, на разрезе сочная, зернистая, пульпа
размягчена. Печень увеличена, края ее закруглены, на
разрезе сочная с хорошо выраженным рисунком долек.
Желчный пузырь сильно растянут, желчь густая, темнобурого или зеленоватого цвета Почки увеличены,
размягчены, граница между корковым и мозговым слоями
стерта. Мочевой пузырь наполнен мочой, окрашенной в
красный цвет различной интенсивности. Книжка наполнена
сухими спрессованными кормовыми массами. Слизистая
кишечника гиперемирована с кровоизлияниями. Сердце
увеличено, мышца его дряблая и бледная. Легкие слегка
отечны.
19.
1.2.
3.
4.
5.
6.
7.
8.
Симптоматическая терапия:
Легкопереваримые корма
Хелатный комплекс медь-кобальт-йод-казеиновой
протокислоты
Гидролизин
Хлористый кальций и глюковит
Камфорное масло, кофеин
Глауберова соль
Молочная кислота
Настойка чемерицы и др.
20.
1.2.
3.
4.
Лекарственные краски – азидин, беренил,
батризин; флавакридин (трипафлавин).
Производные мочевины – гемоспоридин,
наганин (сурамин, байер-250)
Производные диамидина – диамидин,
имидокарб (Имидосан, Бабезан, Пиросан,
Пиростоп).
Производные дименазена – неозидин,
трипонил, верибен.

Медицина
Медицина








